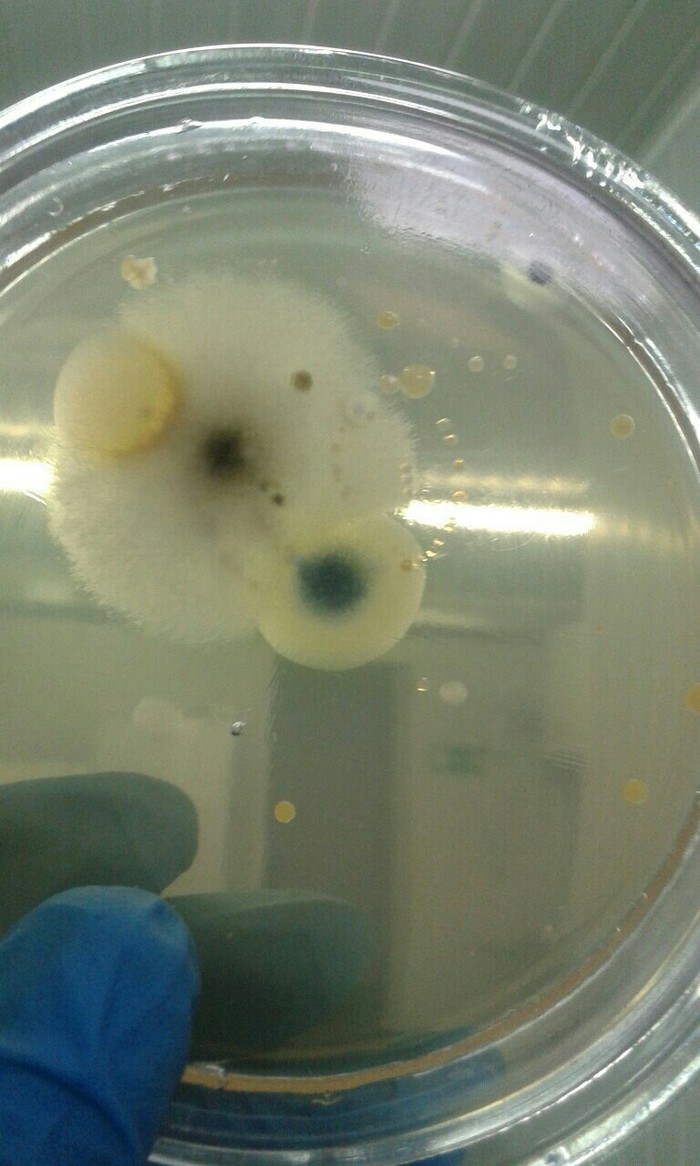

Японский сад в Краснодаре (парк Галицкого)
На пикабу много обзоров из-за границы, а мне хотелось бы показать маленький кусочек Краснодара. Да, Краснодар может быть разным, но я буду его показывать таким, каким вижу. Фото сделаны студией Микра, фотограф Алексей Анисимов. Студия моя, тэг моё :)
Фото сделаны летом :) У нас тут только часть красоты парка, сам Японский сад хоть и небольшой, в масштабах парка, но его многоуровневость и количество локаций впечатляет.
В саду много много растений, птиц и разной мелкой животины.
Весь сад пронизан дорожками и каналами с водой.
Много водоемов с красивыми видами, в воде живут черепахи и рыбы.
Через некоторые проложены мосты с сидушками. Кстати, безопасность тоже радует, для детей в парке достаточно безопасно.
В воде работают очистные и воздушные установки (на фото видно подъем пузырей воздуха от такой установки).
Все выглядит ухоженным и чистым, даже вода. В воде живут какие-то водоросли и растительность. Кстати, на камне в центре видно двух черепах.
Много разных зданий от ресторана до домика для медитации с татами и песочком. Про них, может быть, напишу позже :)
Дорожки в парке разные: из песка, из камней, деревянные, травяные. Асфальта нет :) Кстати, не помню, чтобы асфальт вообще использовался в парке Краснодар (парке Галицкого).
Во так выглядит граница японского сада и парка Краснодар. Слева Японский сад, справа парк :)
Да, попасть в Японский сад сложно, поскольку много желающих, но бесплатно :) Японский сад является частью парка Краснодар, поэтому даже если не попал в сад, то есть что посмотреть рядом. На всей территории парка есть бесплатные аттракционы и локации. Уличной торговли нет, но на территории работают несколько ресторанов и кафе.
В общем - люблю это место :)
Ответ на пост «Пробег не радует»11
Купил в 2010 Микру (глазастую, второго поколения) в салоне б/у машин. Пробег был 89 тыс.
Лето откатал - отлично, а вот зимой начался треш. Пока машина не прогреется, при старте могла заглохнуть, а потом заводилась только через несколько минут. Старался плавно стартовать, но всё равно глох, пару раз посреди перекрёстка.
Отогнал в сервис - мне мастер говорит - растянута цепь, это значит, на ней реально гоняли и пробег не 89к а 150к минимум. Растянута цепь - поэтому фазы открытия и закрытия клапанов не совпадают, и электроника видит неправильное обогащение смеси и тушит мотор на всякий случай. А замена цепи - 60 тр. (по ценам 2010) - потому что надо разобрать полморды для этого.
До весны как-то дотянул, потом продал.
То,что мы не видим
Мой пост начнется со статьи о Таше Штурм-это биолог. В своем опыте(описанной на картинке), она показывает соседей, живущих на нашей коже, в частности на руках.
Эта статья вдохновила меня на проведения своего собственного миниопыта.
Все мы знаем,что мухи не надежные товарищи в плане чистоты и гигиены, слоняются везде и лапки свои не моют. И ладно бы это не касалось нашей еды.
Я Одним прекрасным рабочим днем выпустила из пробирки мушку-дрозофиллу, почувствовать себя часика три свободным мухом. Доступ она имела ко всему, на все этажи и даже в туалет. Где она летала и что творила,я честно не знаю, но поиски ее у меня заняли куда больше времени. В конечном итоге, нашла ее ошивающейся на кухне возле еды. Отловила и посадила в чашку Петри с готовым МПА, буквально минутки на 2.
Животина потопталась изрядно и была с особой благодарностью отправлена в отставку. Через 48 часов нахождения в термостате при 30 градусах появились плоды кутежа дрозофилки.
Прошу любить и жаловать.
Подробно идентифицировать все не стала, т.к. это отняло бы дополнительное время,которого было катастрофически мало...
Просто-напросто мойте руки после посещения общественных мест, ну и с насекомыми ...сделайте выводы сами)
Коротко об экономике
Многие просили высказать своё мнение по поводу влияния Дональда Трампа на экономику.
Победа Трампа была неожиданностью. Многие статистические агенства и букмекерские конторы прогнозировали победу Хиллари Клинтон.
Поэтому финансовые рынки не знают чего им ожидать от Дональда Трампа. Наступил период неопределённости, продолжительность которого может превзойти схожую ситуацию после Brexit.
Если Трамп будет реализовывать свои планы, то есть введёт заградительные тарифы против мексиканских и китайских товаров, то рост экономики США остановится к 2019. (Об этом сообщают многие крупные агенства финансовой информации, например "Рейтер")
Что же касается России. Тут не всё так плохо. У России появилась надежда на ослабление американских санкций, но точно об этом утверждать нельзя. В Америке есть конгресс, который не всегда согласен с президентом. Действительно, на данный момент республиканцев в парламенте большинство. Однако у Дональда Трампа достаточно напряженные отношения с партийными лидерами. Многие соратники отказались поддерживать его перед выборами.
Для принятия многих законов сенату необходимо большинство в 60%, что будет трудно набрать даже если все республиканцы проголосуют за.
Таким образом в краткосрочном периоде мы сможем наблюдать небольшое укрепление рубля на валютном рыке и небольшое укрепление экономики России в целом. Однако, что будет в долгосрочном периоде, прогнозировать достаточно трудно. Если Трамп будет вести изоляционную политику - это ослабит НАТО и усилит позиции России в Европе, что приведёт к снятию европейских санкций, так как поддержка США больше не гарантирована.